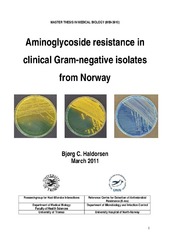
Miniatyrbilde

Mastergradsoppgaver i biologi (Helsefak): Nye registreringer
Viser treff 61-80 av 83
-
Development of an assay for determining PDE5 enzyme activity and for screening of potential inhibitors of the PDE5 enzyme in cancer cells
(Master thesis; Mastergradsoppgave, 2013-05-15)PDE5 is a member of the superfamily of phosphodiesterases, and it is identified as the main mechanism for breakdown of cGMP in mammals. Sildenafil is a well-known inhibitor of the PDE5 enzyme and it is also shown that sildenafil inhibits the ABCC5 transporter pump. ABCC5 is a member of the superfamily of ABC-transporters, and identified as an important transporter for mediating the cellular efflux ... -
Partial characterization of predicted ABCC5 inhibitors by the aid of human erythrocyte inside-out vesicles
(Master thesis; Mastergradsoppgave, 2011-06-24)ABCC5 is a member of the superfamily of ABC-transporters, and it has been identified as an efflux transporter of cGMP. This transporter is also involved in export of antibiotic and cytostatic drugs from target cells, and as such represents a challenge in treatment of cancer and infectious diseases. In order to find inhibitors to ABCC5 mediated drug efflux, compounds predicted as potent inhibitors ... -
Molecular characterization of Norwegian clinical isolates of Escherichia coli hyperproducing the chromosomal AmpC beta-lactamase : a regional spread of an IS911-mediated blaAmpC-hyperexpressing ST131 clone
(Master thesis; Mastergradsoppgave, 2012-05-15)The worldwide dissemination of antimicrobial resistance is a growing problem causing increased morbidity, mortality, and financial costs. β-lactams are an important family of antimicrobial agents and accounts for ~46% of the total antibiotic use for systemic infections in Norway. Resistance to β-lactams can be caused by several factors where the production of enzymes, β-lactamases, is the major ... -
Effects of exogenous hydrogen sulfide administration on cardiac function and reactive oxygen species production : a study in hearts from normal rats and rats with heart hypertrophy or ischemia
(Master thesis; Mastergradsoppgave, 2011-09)Coronary heart disease is the leading cause of death worldwide. Infarct size can be limited by interventions used after the ischemic event like the use of thrombolytic therapy or primary percutaneous coronary intervention. Paradoxically, however, the return of blood flow can also result in additional cardiac damage and complications, referred to as reperfusion injury. It has been shown that reperfusion ... -
Study of interaction between BK virus large T-antigen and agnoprotein
(Master thesis; Mastergradsoppgave, 2011-08)Human polyomavirus BK (BKV) is a non enveloped virus with a double-stranded, circular DNA genome. BKV infects >70% of the human population world-wide. Infection occurs predominantly during childhood and the virus remains in a latent state throughout life in the immune competent individuals. In the context of immunosuppression, however, reactivation occurs and can lead to renal stenosis and interstitial ... -
Directed evolution of Escherichia coli LacZ gene to create diversity in glycosidic bonds hydrolysis
(Master thesis; Mastergradsoppgave, 2011-05-16)Starting with LacZ of Escherichia coli, coding for β-galactosidase, the aim of the thesis project is to apply in vitro directed evolution techniques to help create other glycosidic bond hydrolysis activities. This was done using the main β-galactosidase backbone with limited amino acid sequence change. Any altered glycosyl hydrolase activity would lead to changed substrate specificity. Moreover, ... -
Characterization of the Arabidopsis thaliana homologue of NBR1
(Master thesis; Mastergradsoppgave, 2009-05-15)It is now well established that p62 and NBR1 are selectively degraded by autophagy and can act as cargo receptors or adaptors for the autophagic degradation of ubiquitinated substrates. Research on autophagy in plants is also well under way, but the mechanism by which target substrates are sequestered for autophagic degradation has not been elucidated. The uncharacterized plant protein Q9SB64 shares ... -
A study of the interaction between MAPKAP Kinase 5 / MK5 and DNAJB1
(Master thesis; Mastergradsoppgave, 2011-05-02)The mitogen activated protein kinases (MAPK) are a large and diverse family of protein kinases, contributing to the cells ability to respond to external stimuli by relaying messages in a well orchestrated way until they reach their final destinations. This is achieved through successive phosphorylation events. One member of this large family is mitogen activated protein kinase activated protein ... -
Development of new tissue culture protocols for enrichment of CD4 T cells associated with neonatal alloimmune thrombocytopenia
(Master thesis; Mastergradsoppgave, 2010-11-15)Neonatal alloimmune thrombocytopenia (NAIT) is most commonly caused by destruction of foetal platelets by maternal antibodies reactive to human platelet antigen (HPA)-1a. The activation of antigen-primed B cells to differentiate to antibody-secreting plasma cells usually requires help from CD4 T cells. The strong association between anti-HPA-1a-production and the MHC allele HLA-DRB3*0101 supports ... -
Aminoglycoside resistance in clinical Gram-negative isolates from Norway
(Master thesis; Mastergradsoppgave, 2011-04-06)Aminoglycosides represent an important class of antimicrobial agents. The prevalence of aminoglycoside resistance among Gram-negative bacteria in Norway is low, but an increased prevalence among clinical isolates of Escherichia coli has been observed during the last years. The most prevalent resistance mechanism is aminoglycoside modifying enzymes. In addition, resistance may occur when bacteria ... -
Human articular chondrocytes express Chemerin receptor, ChemR23, which conveys inflammatory signalling
(Master thesis; Mastergradsoppgave, 2008-12-17)Common features of arthritis include destruction of extracellular matrices in cartilage and bone as a result of chronic inflammation. Cartilage deterioration is generally described as a result from the effect of immune cells and their inflammatory mediators. However, recent reports suggest a role of chondrocytes in the initiation of inflammation in joints, and that they play a pivotal role in the ... -
Downstream gene expression of wild type p53 tumor suppressor gene versus mutated and null p53
(Master thesis; Mastergradsoppgave, 2006-11)P53 is a key tumor suppressor and transcription factor protecting us from cancer. The wild type p53 protein functions as a regulatory protein, triggering a variety of cellular responses to different signals. Activation of p53 can lead to cell division arrest, DNA repair, or apoptosis. More than 60% of all human cancers contain p53 mutations. P53 is also reported in many studies to play a role in the ... -
The antioxidant system of arctic seabirds and the effect of HOCs on antioxidant capacity of kidney tissue
(Master thesis; Mastergradsoppgave, 2010-06-15)The arctic is exposed to a wide range of pollutants which originate from industrialized areas located in temperate regions. Halogenated organic contaminants (HOCs) are of special concern due to their persistency and ability to bioaccumulate. Consequently, animals high in the food chain, such as marine seabirds, are prone to accumulate high levels of these compounds. The HOCs are known to increase ... -
King crab proteases: as stimulators of an inflammatory pathway in human airway epithelial cells
(Master thesis; Mastergradsoppgave, 2010-03-22)In these studies, we focus on moricrase (enzyme mixture from hapatopancreas of king crab) as an activator of inflammatory responses in airway cells. Taking under consideration that serine proteases, such as trypsin, are stimulator of interlukin-8 (IL-8). We investigate the role of protease activated receptor 2 (PAR-2) in the inflammation of human pulmonary epithelial cells (A549). A549 cells were ... -
The biological cost of genetic elements.
(Master thesis; Mastergradsoppgave, 2010-03-15)The emergence and increase of antimicrobial resistance among bacterial populations has raised interest in the factor that contributes to this situation. Mobile genetic elements and in particular integrons have been found to play a role in the spread of resistance genes due to their ability to capture and integrate one or more gene cassettes by site-specific recombination. The genes can be integrated ... -
Molecular and biochemical characterisation of naturally occurring hyperexpressed and mutated extended spectrum AmpC beta-lactamases in Norwegian clinical isolates of Escherichia coli
(Master thesis; Mastergradsoppgave, 2009-11-17)Jeg har karakterisert kliniske E. coli isolater, med nedsatt følsomhet for cefalosporiner, på nukleotid og amino syre nivå. -
The world of β-glucans : a review of biological roles, applications and potential areas of research
(Master thesis; Mastergradsoppgave, 2009-05-15)Among many known and tested immunomodulators, polysaccharides isolated from various natural sources occupy a prominent position. An important group of these polysaccharides is represented by the homopolymers of β-glucose, called β-glucans. Their very low-to-negligible toxicity and immunomodulating effects show the promise it has in the therapy of a variety of infectious and cancer illnesses. ... -
Theoretical and experimental studies of thermolysin inhibition
(Master thesis; Mastergradsoppgave, 2008-05-15)Zinc-metalloproteinases play a key role in the biosythesis and metabolism of different bioactive peptides. As a member of zinc-metalloproteinases, thermolysin has served as a model system to study the inhibition mechanism of other metalloproteinases. Inhibitors of thermolysin have considerable potential as therapeutic agents. In the present master thesis, docking calculations were performed and ... -
Et eksperimentelt studium av kreftceller fra livmorhals - Strålesensitivitet, effektutvikling og cGMP nivåer
(Master thesis; Mastergradsoppgave, 2008-06)I denne oppgaven ble kreftceller fra livmorhals bestrålt med gammastråler. Strålingens effekt på celletetthet, celledød og cellesyklus ble undersøkt for å si noe om disse cellenes strålesensitivitet. Den ekstracellulære konsentrasjonen av cGMP ble også målt. Dette sykliske nukleotidet har relevans fordi det har vist seg at nivået av cGMP går ned etter behandling hos pasienter med livmorhalskreft. -
A molecular study of putative pili structures in Enterococuus faecium
(Master thesis; Mastergradsoppgave, 2008-12)Infections caused by Enterococcus faecium have increased over the last few decades. In this thesis there has been an attempt to identify putative pili proteins in E. faecium. The putative genes were ligated into a pENTR vector; the insert was sequenced to check the orientation, sequence, length and ends. Then the putative genes were recombined into a pDEST vector for expression. The expression showed ...


 English
English norsk
norsk